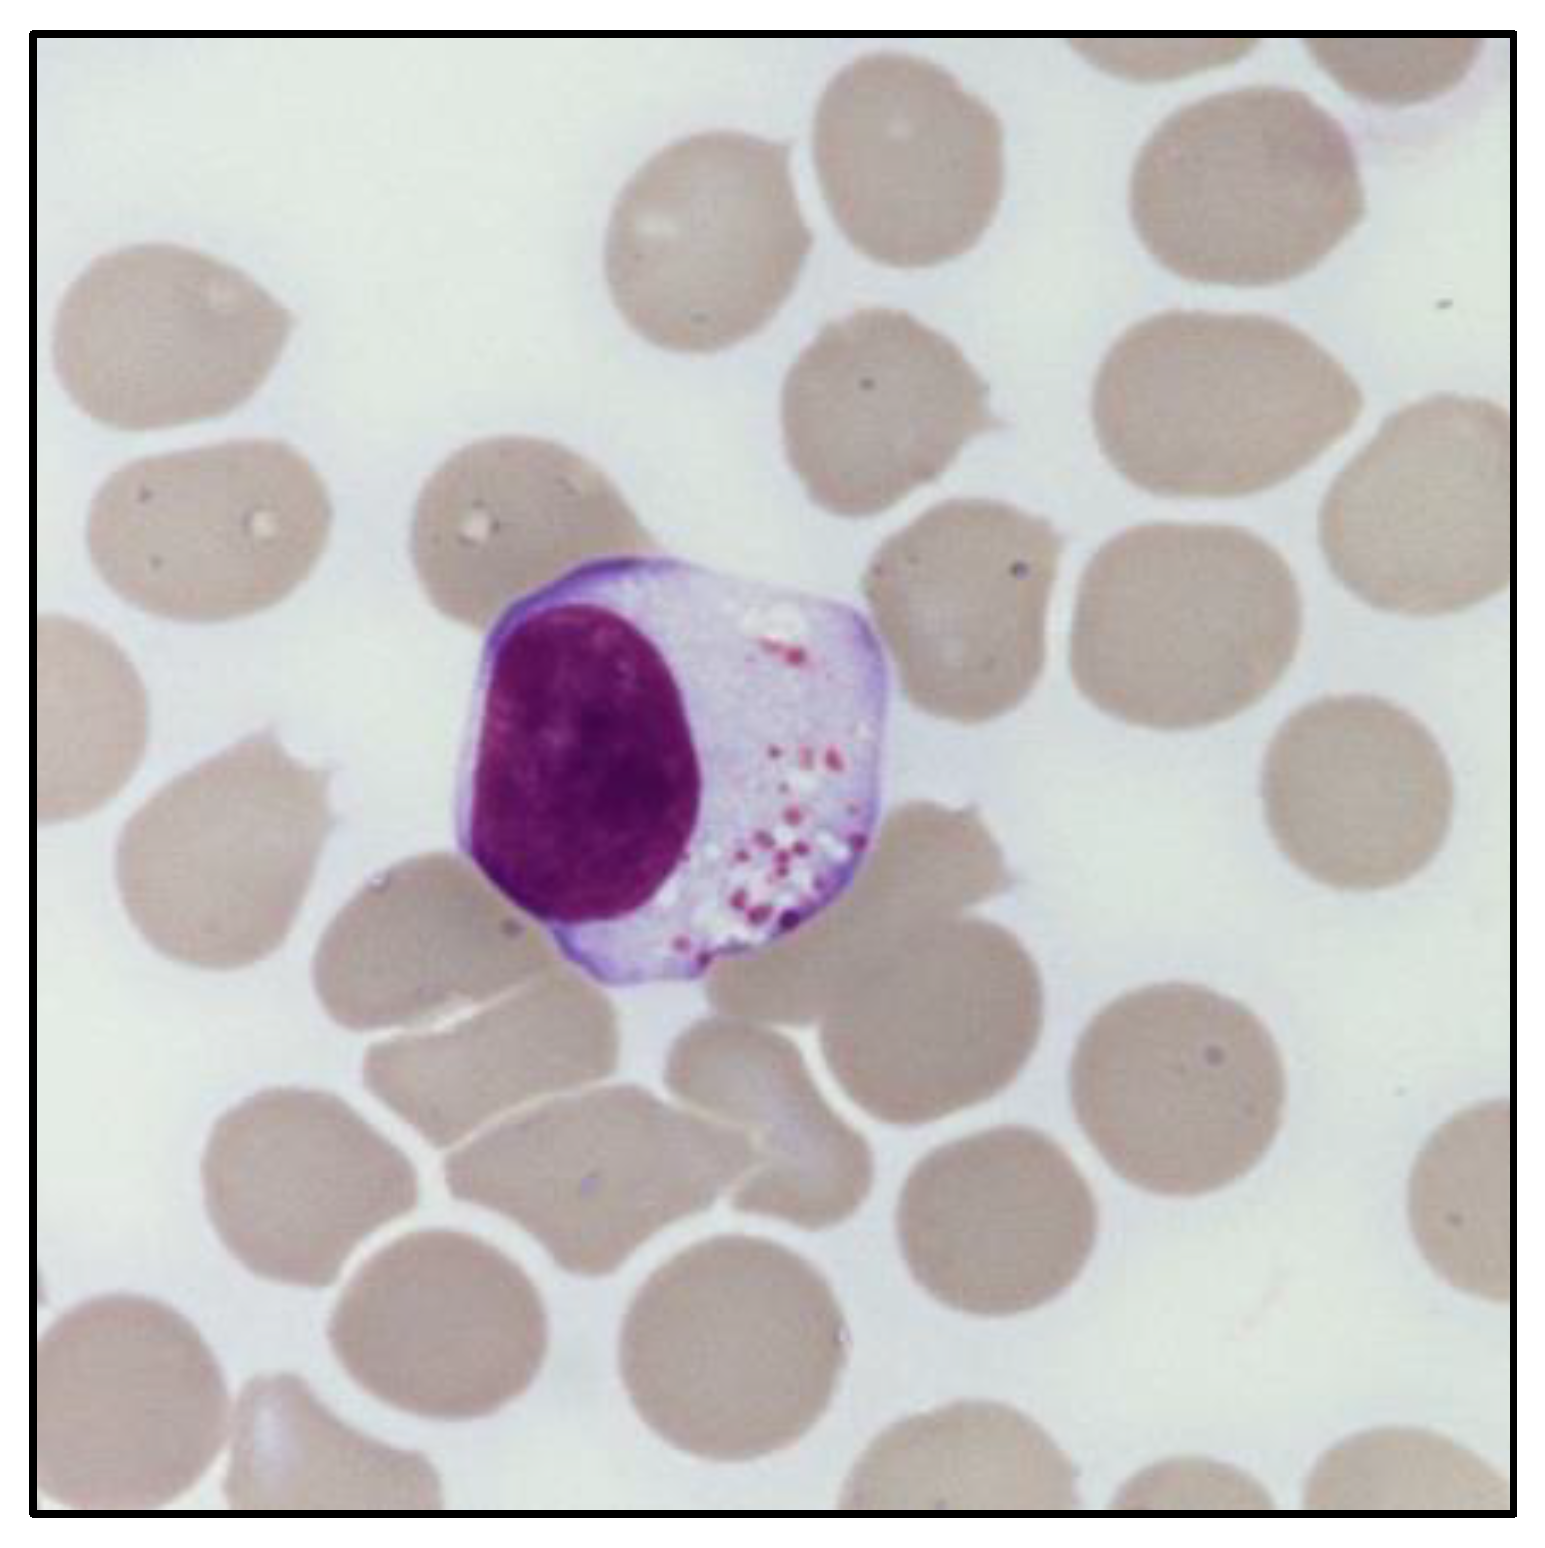
Cancers 14 05236 g001

Simple Summary
The clonal expansions of large granular lymphocytes are frequently detected in a wide spectrum of hematological and immune diseases. This clinical overlap, especially in patients with unexplained cytopenia, makes their diagnostic classification particularly challenging. Herein, we aim to elucidate the boundaries between LGL leukemia (LGLL) and LGL clonal expansions. We also discuss the relevance of LGL clone detection in the diagnostic algorithm, as they might acquire different pathogenetic roles according to the diverse clinical setting.
Abstract
Clonal expansions of large granular lymphocytes (LGL) have been reported in a wide spectrum of conditions, with LGL leukemia (LGLL) being the most extreme. However, the boundaries between LGLL and LGL clones are often subtle, and both conditions can be detected in several clinical scenarios, particularly in patients with cytopenias. The intricate overlap of LGL clonal expansion with other disease entities characterized by unexplained cytopenias makes their classification challenging. Indeed, precisely assigning whether cytopenias might be related to inadequate hematopoiesis (i.e., LGL as a marginal finding) rather than immune-mediated mechanisms (i.e., LGLL) is far from being an easy task. As LGL clones acquire different pathogenetic roles and relevance according to their diverse clinical settings, their detection in the landscape of bone marrow failures and myeloid neoplasms has recently raised growing clinical interest. In this regard, the current availability of different diagnostic techniques, including next generation sequencing, shed light on the relationship between LGL clones and cytopenias, paving the way towards a better disease classification for precision medicine treatments. Herein, we discuss the clinical relevance of LGL clones in the diagnostic algorithm to be followed in patients presenting with cytopenias, offering a foundation for rational management approaches.
1. Introduction
Large granular lymphocytes (LGLs) functionally represent the cytotoxic arm of the immune system. Their physiological activation and expansion is generally transient, polyclonal, and self-limited. However, chronic antigenic pressure or acquired molecular alterations might promote the selection of an LGL clone as part of a normal immune response, leading to its aberrant proliferation, eventually resulting in full-blown LGL leukemia (LGLL) [1,2]. Looking beyond the boundaries of LGLL disease, LGL clonal expansions have been reported in a wide spectrum of conditions, including autoimmune disorders, immunodeficiencies, and clonal myeloid diseases [3,4,5]. Cytopenias are the narrative thread and are the most common clinical presentation of almost all of these conditions, highlighting the need to properly address differential diagnosis [6].
While in LGLL the cytotoxic clone is responsible for the presence of cytopenias, whose severity represents the main indication of treatment start [7], the potential contribution of LGL clonal expansions in the above-mentioned conditions is still unclear. This might be part of an immune surveillance reaction, as well as the result of a common etiopathogenesis, also contributing to disease progression. However, in most cases, the peculiar concurrence of LGL clonal expansion with other disease entities still has a controversial impact on their prognosis and outcome. Moreover, a recent study highlighted a high degree of overlap between leukemic and non-leukemic T cell receptor (TCR) repertoires via possible common target antigens, further expanding the pathogenic routes leading to disease manifestations [8]. In such a scenario, the detection of LGL clonal expansions has recently raised increased interest, as the precise determination of its clinical significance is oftentimes unclear.
Herein, we focus on the relevance of LGL clones with respect to diagnostic orientations, by stressing the role of a multi-step approach based on the investigation of discrete biological alterations and according to the diverse clinical settings. In particular, we critically discuss some hints that could help to properly address differential diagnoses in the presence of LGL clones and cytopenias, two clues that could be the sentry of a variety of underlying pathological conditions.
2. Detection and Characterization of LGL Clones
LGLs account for approximately 10–15% of peripheral blood mononuclear cells (PBMC), with an absolute count ranging from 0.2 to 0.4 × 109 LGL/L. These types of cells can be CD3+ T cytotoxic lymphocytes or CD3- Natural Killer (NK) cells, which are two distinct but functionally related cell types, with cytotoxic properties [9].
Physiological LGL expansions are generally polyclonal and related to pathogenic noxae or antigenic stimuli. Upon antigen clearance, engaged cells undergo activation-induced cell death (AICD), which is a central mechanism to maintain immune homeostasis. Conversely, a chronic antigenic stimulation, as well as additional cooperating events (i.e., inflammation, impairment of AICD, genetic lesions, and constitutive activation of pro-survival pathways), might promote the selection of an immunodominant LGL clone, which persists and proliferates over time [10].
The presence of an expanded LGL population can be defined based on its absolute count (i.e., greater than 0.5 × 109/L). In this regard, peripheral blood (PB) smear can provide an immediate evaluation of the LGL percentage in relation to the total lymphocytes, which is useful to estimate the absolute LGL count. Morphologically, LGL are characterized by a size (≃15–18 μm) larger than the other circulating lymphocytes [9]. In particular, these cells have a round or reniform nucleus and an abundant pale cytoplasm with characteristic azurophilic granules, containing cytolytic components such as perforin and granzymes. Of note, clonal LGL do not show any morphological difference compared to polyclonal LGL, nor any distinctive signs of clonality (Figure 1). The only exception exists in the cytological atypia observed in leukemic NK cells of patients diagnosed with Aggressive NK cell leukemia (ANKL) [11].
Figure 1.
Morphology of a large granular lymphocyte. May–Grunwald Giemsa staining of large granular lymphocytes in the PB of a patient with LGL leukemia. Magnification: optical microscope 1000×.
Flow cytometry (FC) furthers the information obtained by PB smear, helping in the first discrimination between CD3+ T-LGL and CD3− NK cells. In detail, T-LGLs are terminal-effector memory T cells (TEMRA), which typically show a CD3+, CD4−, CD5dim, CD8+, CD27−, CD28−, CD45RA+, CD45RO−, CD57±, CD62L−, CCR7−, CD122+ phenotype. These can be equipped with an αβ-TCR or, less frequently, with a γδ-TCR. Conversely, NK cells are devoid of TCR and exhibit a CD2+, sCD3−, CD3ε+, CD4−, CD8+, CD16+, CD56+, CD57± phenotype. The aberrant expression of NK cell markers and receptors, including Killer Immunoglobulin-like Receptors (KIR) and the CD94/NKG2 heterodimers, is often seen in both clonal T- and NK-LGL proliferations [12,13].
In the setting of an expanded LGL population, clonality should be assessed to differentiate reactive from clonal expansions. Molecular-based approaches and FC are currently the gold standard [1]. The clonality of the T-cell lineage can be detected by polymerase chain reaction (PCR), evaluating the TCR repertoire [14]. In addition, next generation sequencing (NGS) of the antigen-binding region (i.e., the complementarity determining region 3, CDR3) of TCR provides information regarding the specific CDR3 sequences and the size of the immunodominant clonotype [15]. Flow cytometer analysis of the TCR Vβ expression offers an additional and rapid approach to assess the preferential expression of one TCR-Vβ segment [16]. Remarkably, recent advances in high-sensitive next-generation FC are now extending the current diagnostic possibilities. In this regard, evaluation of the constant region 1 of the T-cell receptor chain (TCRBC1) by FC has recently been proposed for assessing T clonality [17].
The identification of clonality in NK cell proliferations is more difficult, given the absence of TCR as a possible marker. An analysis of the restriction fragment length polymorphism (RFLP) has been used in a few cases, but this evaluation is gender-related. Otherwise, evidence of a restricted pattern of KIR or NKG2 expression, provided by FC, is accepted as a surrogate marker of clonal expansion [18,19,20].
3. Large Granular Lymphocytes Leukemia: From Phenotypic to Genetic Heterogeneity
According to well-defined criteria, the chronic expansion of a clonal LGL population in the peripheral blood meets the diagnosis of LGL leukemia (LGLL) [1]. Based on the recently published fifth edition of the World Health Organization (WHO) Classification of Haematolymphoid Tumours (Lymphoid Neoplasms), LGLL is classified within the Mature T-cell and NK-cell neoplasms section [20].
The disease encompasses a remarkable clinical, phenotypic, and genetic heterogeneity. According to the immunophenotype of the leukemic clone, three main subtypes can be recognized: T-large granular lymphocytic leukemia (T-LGLL), NK-large granular lymphocytic leukemia (NK-LGLL, previously listed as a provisional entity, i.e., Chronic lymphoproliferative disorder of NK cells) [21], and aggressive NK-cell leukemia (ANKL).
T-LGLL and NK-LGLL are the most frequent forms of the disease (85% and 10% of cases, respectively) [13], while ANKL is a rare variant (accounting for approximately 5% of cases), typically seen in Asian populations and characterized by EBV positivity [22].
Within T-LGLL, additional immunophenotypic subtypes can be identified [20]. Based on the type of TCR, two variants (Tαβ- and Tγδ-LGLL) can be distinguished. Moreover, beyond the canonical CD4−/CD8+ T-LGLs expansion (CD8+ T-LGLL), a CD4+/CD8neg/dim variant (CD4+ T-LGLL) has been described in ~30% of cases [23,24]. This distinction does not represent just a formal classification, as accumulating evidence is showing that these subsets are characterized by different biological and molecular features [24,25,26]. Several molecular alterations contribute to the survival and proliferation of the expanded LGL clone [1], with some of them being a signature of a precise disease subtype [27]. Among these, STAT3 and STAT5b hyperactivating mutations represent the main genetic lesions of leukemic LGL, and are particularly relevant because of their association with phenotype, clinical manifestations, and disease prognosis [26,28]. In detail, STAT3 mutations are common in CD8+ Tαβ-LGLL and Tγδ-LGLL (Vδ2-/CD56-) subsets and are associated with cytopenias and reduced overall survival [24,29,30]. Conversely, STAT5b mutations are more typically present in CD4+ T-LGLL and have also recently been found also in Tγδ-LGLL (Vδ2+/CD56+) [30,31]. In contrast with STAT3, STAT5b mutations are generally linked to an indolent course, similar to that of STAT3 wild-type cases [30]. Rarely, STAT5b mutations can be found in association with the peculiar CD3+/CD8+/CD4−/CD16−/CD57−/CD56+ phenotype and, in this case, are associated with an aggressive T-LGLL variant characterized by a poor prognosis [32]. In the NK-LGLL subtype, STAT3 mutations usually occur in LGL clones expressing CD16high/CD56dim/neg/CD57− and clinically manifest with severe neutropenia [33], whereas STAT5b mutations have rarely been detected [34].
4. T-LGLL and NK-LGLL Diagnosis: Stringent Criteria and Recommended Analyses
A diagnosis of LGLL needs to be considered in the context of an integrated approach, including the phenotypic and molecular characterization of the LGL clone and an evaluation of the clinical context.
A temporal criterion with a chronic LGL expansion, generally lasting more than 6 months since its initial detection, is essential to first exclude reactive conditions. Of note, a lymphocytosis of at least 2 × 109 LGL/L was historically mandatory for fulfilling a LGLL diagnosis. Based on the acquired experience, a reduced threshold of 0.5 × 109 LGL/L in PB is now commonly accepted [20], if other criteria for the disease are present (evidence of clonality, typical immunophenotypic pattern, and clinical features). Proof of clonality can be obtained, as described above, according to the proliferating cell type (T- or NK-LGL).
FC is a milestone in the diagnostic work-up of LGLL. As aforementioned, patients exhibit a high phenotypic heterogeneity, albeit with a strong correlation between some immunophenotypic features and the occurrence of neutropenia (the hallmark of the disease). In detail, neutropenic T-LGLL patients are often characterized by a peculiar combination of LGL markers (i.e., CD8+/CD16+/CD56−/CD57± in the Tαβ forms or Vδ1+/CD16+/CD56−/CD57+ in the Tγδ proliferations) [29,30,31]. Similarly, neutropenic NK-LGLL patients are typically characterized by a CD16high/CD56dim/neg/CD57- phenotype [33]. In this context, FC analysis might acquire an added value, providing relevant information to precisely identify LGLL and cases requiring clone-targeting treatments.
In some instances, the absence of a well-defined LGL lymphocytosis or evidence of clonality lead to a gray zone. The integrated evaluation of the clinical context and molecular information, provided by BM investigation and genetic analyses, could help the confirmation of a suspected diagnosis of LGLL. In particular, a diagnosis of LGLL requires the exclusion of T-cell clones of uncertain significance (T-CUS), a condition mimicking T-LGLL in terms of the immunophenotype but devoid of other clinical or laboratory features supporting a diagnosis of T-cell malignancy [35,36].
BM aspirate/biopsy are the mostly recommended procedures when the diagnosis is not straightforward [37]. In particular, BM morphology might help to elucidate the etiology of unexplained cytopenias, ruling out other possible differential diagnoses. The BM of LGLL patients is generally characterized by a moderate or marked hypercellularity and an interstitial lymphoid infiltration, with clusters of at least eight CD8+/TIA1+ cells or six granzyme B+ lymphocytes as a common histopathological finding [38,39]. A decrease in granulocyte precursors, combined with a left-shifted myeloid maturation, is a typical feature observed in BM of neutropenic LGLL patients. BM biopsy may also reveal the presence of fibrosis, usually increased in the BM of LGLL patients, with a grading ranging from moderate to severe in approximately 50–60% of cases, irrespective of prior treatments [40].
Cytogenetic abnormalities in LGLL are rarely investigated, because of the difficulty growing LGL in vitro. Overall, less than 10% of cases display distinct chromosomal aberrations (including 12p and 14q inversion, 5q deletion, and trisomy of chromosomes 3, 8, and 14) [13]. Conversely, molecular genetics might be useful to confirm the non-reactive nature of a LGL proliferation, as previously discussed (e.g., identification of STATs mutations). In particular, a novel algorithm was recently developed to classify NK-cell proliferations. The score combines FC (in terms of KIR phenotyping) and molecular profiling data with a positive predictive value of 93%. In this regard, STAT3 and TET2 mutations, identified with a high frequency in NK-LGLL cases (27% and 34%, respectively), have been proposed as a new diagnostic hallmark for this disease. Of note, these genetic lesions have been found to be associated with different clinical features, identifying two distinct subsets of patients. In detail, STAT3-mutated NK-LGLL exhibit a CD16High phenotype, a decrease in hemoglobin concentration (with respect to TET2-mutated NK-LGLL and to reactive NK lymphocytosis), and a lower neutrophil count (compared with reactive NK expansions). In contrast, TET2-mutated NK-LGLL exhibit a CD16low phenotype and are associated with a low platelet count and the coexistence of other hematologic malignancies [41]. In addition, somatic mutations in the C-C motif chemokine 22 (CCL22) gene were recently described in up to 27% of NK-LGLL patients, and could aid in discerning clonal from reactive lymphocytosis. Similarly to TET2 mutations, these genetic lesions are associated with a CD16 low phenotype. Moreover, they have been found to be mutually exclusive with STAT3 mutations [42].
Additional new mutations have also been detected in CD4+ T-LGLL [43], suggesting that the genetic landscape of the disease is evolving and mutational analyses are becoming increasingly important in distinguishing discrete disease subsets [44].
5. LGLL-Related Cytopenias
Although heterogeneous, the clinical course of LGLL is typically characterized by cytopenias [45]. Chronic isolated neutropenia is the most typical disease manifestation and it has been observed in up to 80% of patients, with severe neutropenia (<0.5 × 109/L) characterizing up to 17–24% of cases. Neutropenic patients usually present with recurrent oral ulcerations and bacterial infections, and more rarely viral and fungal infections. Severe septic complications may also occur and represent the primary cause of disease-related death in approximately 5–10% of cases [6,9,46].
Recent evidence highlights that neutropenic T-LGLL patients share a distinctive immunophenotypic signature, which may guide their early identification. At a molecular level, a high incidence of STAT3 mutations has been observed in both T-LGLL and NK-LGLL patients with neutropenia [28,29,30,33]. The pathogenesis of LGLL-related neutropenia has been reported as multifactorial, including immune alterations, BM infiltration/substitution, and cell-mediated cytotoxicity [47,48]. Among these, Fas-mediated apoptosis of mature neutrophils or myeloid progenitors represents one of the most commonly accepted mechanisms. Indeed, high levels of soluble FasL are detectable in the sera of neutropenic patients, as a result of a defective expression of miR-146b [27].
Beyond neutropenia, anemia (including pure red cell aplasia (PRCA)) and thrombocytopenia are other relevant manifestations [24,49,50,51,52,53]. While great efforts have been devoted to the characterization of neutropenic patients, the pathogenesis of anemia and thrombocytopenia has been less investigated.
6. The Boundaries between LGLL and Autoimmunity in the Pathogenesis of Cytopenia
Ideally, from a nosological standpoint, LGLL could be placed at the intersection between a clonal lymphoproliferative disorder, autoimmunity, and chronic inflammation [1,54]. In particular, the discrete association of LGLL with autoimmune disorders has emphasized the need for a refinement of diagnostic boundaries, both conditions being characterized by a spectrum of immune dysregulations and overlapping clinical manifestations, ultimately leading to the occurrence of chronic cytopenias [55].
Rheumatoid arthritis (RA) is the most frequent autoimmune condition observed in LGLL patients, and it is commonly related to T-LGLL [56]. A minority of RA patients may also develop Felty’s syndrome, a disorder characterized by the typical triad of RA, neutropenia, and splenomegaly. Remarkably, up to 40% of FS cases present a concomitant LGLL [57,58] and, in this specific instance, the integration of clinical manifestations with signs of the autoimmune disease might help in defining the nature of cytopenias [59].
Otherwise, the immune-mediated pathogenesis of cytopenia(s) in LGLL are related to the co-existence of autoimmune hemolytic anemia (AIHA), PRCA, and immune thrombocytopenia (ITP). In LGLL patients, anemia embodies, at best, the dichotomy between precursors and peripheral cell destruction. AIHA has been estimated to be the cause of anemia in 5% of LGLL cases [1,60,61,62]. As the underlying mechanism involves humoral immunity against mature erythrocytes, a diagnostic suspect of AIHA may be confirmed through the direct Coombs test (DCT). BM biopsy, instead, is required to confirm PRCA, reported in approximately one-third of T-LGLL patients presenting with isolated anemia [53]. A diagnosis of PRCA can be based on the evidence of a marked decrease or the absence of erythroid precursors and a lower reticulocyte percentage (at least <1%) [63]. No significant difference in terms of overall survival was observed in T-LGLL patients, irrespective of the presence of PRCA, suggesting that anemia, regardless of its pathogenesis, may represent an epiphenomenon of LGLL [53].
The detection of anti-platelet autoantibodies can instead suggest a diagnosis of ITP, reported in approximately 4% of LGLL cases [64]. It is noteworthy that a potential contribution of hypersplenism, which is a frequent feature of LGLL patients [50], cannot be excluded in thrombocytopenic cases, although it does not seem to correlate to the severity of cytopenia(s) [65]. LGLL-related amegakaryocytic thrombocytopenia (AMT) has also been reported [66,67] with mechanisms of immune mimicry towards the megakaryocytic lineage as potential pathobiological routes.
7. The Origin of Cytopenia(s): Is the LGL Clonal Expansion the Culprit?
In the context of chronic unexplained cytopenia, the diagnostic detection of an underlying LGL clonal expansion has probably been underestimated. On the other hand, pointing at the LGL clone as the main or unique cause of cytopenia would be reductive, as the association of these two entities, LGL clones and cytopenia, does not lead to a unique nosological entity. The diagnostic process is likely to be nuanced by the evidence of concurrent LGL clonal expansion in association with other hematological conditions, such as bone marrow failure syndromes (BMFS) and clonal myeloid diseases, which are all able, per se, to explain the presence of cytopenia [68].
Furthermore, increasing evidence has highlighted the frequent concurrence of LGL clones in the setting of conditions affecting the myeloid compartment, from clonal hematopoiesis of the indeterminate potential (CHIP) to myelodysplastic neoplasms/acute myeloid leukemia (MDS/AML) [5,69].
One could speculate that such peculiar associations may represent an extreme condition caused by common age-related pathogenetic mechanisms, such as common inciting stimuli, inflammatory environment, and mutational stress. (Figure 2A). With respect to this hypothesis, the finding of a shared sero-reactivity against a human T-cell leukemia virus epitope (i.e., BA21) in both LGLL and BMFS patients suggests that these diseases might share a common pathogenesis [70]. Regarding the occurrence of common genetic lesions, concurrent STAT3, DNMT3A, and TET2 mutations were found in a patient with concomitant T-LGLL and CHIP [71]. Moreover, a recent study showed that somatic TET2 mutations were shared by myeloid and NK cells in 3 out of 4 NK-LGLL cases, further supporting the hypothesis of common driver pathogenetic mechanisms [41].
Figure 2.
Coexistence of LGL and myeloid clones. Different scenarios can be hypothesized to explain the peculiar concurrence of LGL clones with myeloid diseases. (A) Common age-related mechanisms occurring in the BM compartment (for instance genetic lesions or inflammatory stimuli) might be involved in the pathogenesis of both conditions, i.e., LGL clonal expansion and myeloid disease. (B) LGL expansion might represent an immune reaction to the presence of aberrant HSCs. (C) A cytotoxic LGL clone might exert a pathogenetic role, causing damage in the myeloid compartment and favoring the development of a myeloid disease. Note: BM, bone marrow; HSC, hematopoietic stem cells; LGL, large granular lymphocytes. The figure was created with Biorender.com.
A second possible scenario is that LGL clonal expansion might constitute a reactive phenomenon involved in tumor surveillance (Figure 2B). Under certain circumstances, the LGL-mediated immune surveillance might lead to an excessive eradication of BM cells, resulting in a hypocellular BM. Otherwise, immune evasion mechanisms might favor the establishment of a myeloid disease, which may develop simultaneously with the persistence of an expanded cytotoxic LGL clone.
Vice versa, clonal LGL expansions might have a causative role in the pathophysiology of myeloid diseases (Figure 2C). In this regard, inflammatory cytokines and soluble factors involved in the activation of different signaling pathways (such as IL-6, IL-15, and soluble Fas Ligand), produced and released by LGL cells [72], might exert chronic inflammatory pressure on BM HSC, resulting in persistent immune deregulation. In support of this latest hypothesis, we recently reported the association of clonal T cell expansions in high-risk hypoplastic MDS (MDS-h) patients [73].
The development of cytopenia can be the final result of a wide spectrum of alterations, occurring either in the BM compartment, at the level of myeloid precursors, or involving mature cells in peripheral sites. In some instances, the pathogenesis of cytopenia can also be multifactorial. In this context, it is still difficult to predict whether the LGL clone represents a pathogenetic determinant or instead a coincidental finding. Further investigations are needed to finally clarify the nature of such immune alterations.
8. LGL Clones as a Clue in the Differential Diagnosis of Cytopenic Patients
In the landscape of BMFS, LGL clonal expansion may be considered as an additional clue for diagnostic purposes, rather as than the culprit of the cytopenia(s). In this regard, a multi-step approach is required to properly establish a diagnosis. Figure 3 provides an integrated view of the diagnostic procedures that should be considered according to the clinical setting and the available molecular data.
Figure 3.
Diagnostic analyses recommended in case of unexplained cytopenia(s) and evidence of T- or NK-LGL clonal expansion. Note: Each test represents a mere hint towards a diagnostic definition and it is not enough for establishing a precise diagnosis. Germline tissue is intended as non-hematopoietic tissue (such as skin fibroblasts, nails, or buccal swab, according to local practice). MDS, when a specific subgroup is not specified, requires a specific diagnostic work-up in order to define features necessary for classification, according to the fifth WHO classification [20]. Abbreviations: AMT, amegakaryocytic thrombocytopenia; AA, aplastic anemia; BMFS, bone marrow failure syndromes; GoF, Gain of Function CCUS, clonal cytopenia(s) of undetermined significance; DTA, DNMT3A-TET2-ASXL1; DCT, direct Coombs test; GM, germline; IEI(s), inborn errors of immunity; LGLL, large granular lymphocytic leukemia; MDS, myelodysplastic neoplasms; MDS-h, hypoplastic MDS; MDS-IB, MDS with increased blasts; PNH, paroxysmal nocturnal hemoglobinuria; PB, peripheral blood; PRCA, pure red cell aplasia; t-NGS, targeted next generation sequencing; VAF, variant allele frequency. This arrow (↑) indicates an increase, while the other one (↓) a decrease. The table was created with Biorender.com.
8.1. Bone Marrow Smear and Biopsy
An evaluation of the BM morphology could provide immediate information. Dysgranulopoiesis and dysmegakaryopoiesis, with evidence of dysplasia in at least 10% of granulocytic precursors and megakaryocytes, point towards myelodysplastic neoplasms (MDS), in which cytopenia represents a condition for the diagnosis [74,75]. Dyserythropoiesis (even if isolated) is, instead, a less univocal feature, considering the overlap with the aplastic anemia picture [76]. Conversely, a deep reduction of the erythroid precursors in patients with both anemia and an LGL clonal expansion could support PRCA as the dominant disease entity [63].
Focusing on BM populations, an increase in BM blasts over 5–9% or 10–19% may support the diagnosis of MDS-IB1 and MDS-IB2, respectively [20]. In addition, BM biopsy, which is often underestimated and is considered as a complementary procedure, is able to clarify some nuanced features, such as BM cellularity. For the first time, the fifth edition of the WHO classification has recognized hypoplastic MDS (MDS-h) as a distinct clinical entity, defined according to an age-adjusted BM cellularity ≤25%. The relevance in distinguishing this rare subgroup of MDS is related to their frequent overlap with LGL clonal expansions, suggesting the involvement of peculiar immune mechanisms in disease pathogenesis and prognosis [73,77].
8.2. Bone Marrow/Peripheral Blood Flow Cytometry
Some currently available FC scores, such as the Ogata and Red scores, are helpful tools to support a diagnosis of MDS. Although not sufficient for MDS diagnosis, by integrating the information obtained from BM morphologic evaluation, these scores may help in defining a diagnosis of MDS as opposed to non-clonal cytopenia [78,79].
Concerning differential diagnosis with PRCA, FC is able to prove the absence of CD117+ and CD105+ erythroblasts in BM samples, which is a typical feature of PRCA, together with evidence of a severe reduction/absence of proerythroblasts; despite its diagnostic relevance, this approach is not currently standardized and PRCA remains a diagnosis by exclusion [63,80].
FC analyses of PB samples are also essential for the diagnostic work-up of paroxysmal nocturnal hemoglobinuria (PNH) clones [81]. The size of PNH clones, along with comprehensive BM characterization and clinical features, can guide towards PNH diagnosis, a condition in which hemolytic anemia is complement-mediated. Otherwise, in the context of BMFS patients usually have smaller, subclinical PNH clones, defined as an accompanying finding [82].
8.3. Bone Marrow Conventional Karyotyping and Myeloid Gene Mutation Analysis
Considering the recurrence of LGL clones in the landscape of BMFS, conventional karyotyping is helpful for clarifying the cause of ineffective hematopoiesis. Cytogenetic abnormalities in AA are rare, while their incidence increases in MDS-h and even more in normo/hyperplastic MDS. Although there are no univocal abnormalities associated with a precise diagnosis, monosomy 7 and 7q deletion are consistent with MDS rather than AA [83].
Targeted next generation sequencing (t-NGS) techniques applied to the myeloid compartment have furthered our understanding of the genetic background in which LGL clones can emerge. Especially when BM dysplasia is the only additional finding in unexplained cytopenia(s) cases (without blast increase nor any cytogenetic abnormalities) a proper MDS diagnosis may be challenging, particularly for younger patients with hypocellular BM, where a correct differential diagnosis with other BMFS must be made. NGS could provide some additional information for diagnostic guidance, as over 90% of patients with myeloid diseases have been shown to present somatic mutations [84]. The occurrence of mutations in DNMT3A, TET2, and ASXL1 genes in patients with LGLL has also been reported, suggesting their coexistence with CHIP or, at least in the presence of cytopenia(s), with clonal cytopenia of undetermined significance (CCUS) [5]. Clonal burden in terms of variant allele frequency (VAF) is typically lower in CCUS than in frank MDS [85]. However, typical CHIP mutations present with a higher clonal burden in LGLL compared with healthy individuals with CHIP, perhaps because of the expression of a more advanced disease status [5]. Accordingly, even in cases not fulfilling LGLL diagnostic criteria, the joint finding of cytopenia(s) and myeloid mutations, in the absence of BM dysplasia, might be ascribed to CCUS.
High-VAF mutations and the detection of multiple genetic variants in myeloid genes is highly indicative for an MDS diagnosis. Of note, different studies have shown that the co-occurrence of MDS with LGL clones could be related to the recurrence of some mutated genes, such as NRAS [86], ASXL1, STAG2 [87], and U2AF1, while some disease-defining genes, such as SF3B1, are mutated equally in MDS/LGL and MDS alone [69]. BCOR/BCORL1 mutations are common in aplastic anemia patients [88,89]; their presence in LGLL without evidence of any other hematological disorders suggest that they may occur both in myeloid and lymphoid cells [5].
8.4. The Landscape of Germline Immune-Hematological Disorders
The widespread availability of large-scale genomic sequencing has recently promoted the investigation of germline variants associated with non-syndromic BMFS cases, which can occur without any other clinical signs except for cytopenia(s). The current knowledge of these variants is indeed leading to a reassessment of the boundaries initially conceived for some phenotypes. This is the case of DDX41, originally classified as one of the most commonly mutated genes in familial myeloid neoplasms, whose variants are now also recognized in hematolymphoid neoplasms, such as T-LGLL and multiple myeloma [90].
Mutational analysis of this inherited predisposing gene should be included in the diagnostic routine, considering that DDX41 variants are not associated with distinctive pathologic features and the median age of disease onset overlaps with de novo cases.
Especially in younger patients, LGL clonal expansion and cytopenia could suggest other peculiar inherited disorders. In particular, inborn errors of immunity (IEIs) may confer susceptibility to chronic antigen exposure that lead to the clonal proliferation of lymphoid cells. T-LGL clonal expansions (sometimes fulfilling T-LGLL criteria) have been associated with germline mutations in ADA2 [91], CARD11 [92], and LRBA [93]. The recent discovery of TLR8-GoF variants confirmed the importance of investigating genetic variants in IEIs, which are not necessarily defined based on their germline nature. TLR8-GoF variants, indeed, can occur alternatively as germline events or as postzygotic ones, leading to somatic mosaicism [94]. These variants could determine chronic neutropenia as the dominant cytopenia, accompanied by an immune dysregulation phenotype and T-cell expansion in BM. The combination of defects in immune function and BM cell production place this disorder at the interface between two distinct landscapes of rare diseases, BMFS and IEIs [95]. In other cases, LGLL was reported in common variable immunodeficiency (CVID) [96], Hyper-IgM syndrome [97], and even acquired conditions such as Good syndrome [4], oftentimes without a proper genetic diagnosis. A diagnostic work-up in IEIs patients frequently includes in-depth T-cell subset characterization by FC, which might lead to the identification of an LGL expansion [98]. In these cases, assessment of clonality could be crucial to obtain new insights in how lymphoproliferation may occur in the clinical setting on IEIs. Considering that primary immune regulatory disorders (PIRDs) mainly present with autoimmune cytopenias as the first clinical sign [99], cytopenia(s) and LGL clonal expansions may possibly represent two sides of the same coin in the field of primary immunodeficiencies.
9. Conclusions
LGL clonal expansion can be detected in a wide spectrum of conditions, including LGLL, a rare and heterogeneous hematological disease characterized by chronic cytopenias as the most frequent clinical manifestation. Despite the efforts in improving molecular diagnostics, the boundaries between LGLL, intended as an independent disease entity, and LGL clonal expansion still lie in ill-defined diagnostic shadowlands. Of note, LGL clonal expansions might acquire different clinical relevance according to the setting in which they occur, ranging from both hematological to autoimmune disorders and immunodeficiencies. In some cases, LGL clones have been associated with worse survival outcomes, being recognized as being responsible for complex clinical phenotypes. However, whether LGL clones represent a reactive immune response or, vice versa, they are part of a pathogenetic mechanism that still remains a matter of debate. Beyond their still unclarified pathophysiologic role, LGL expansions should be considered an additional clue to guide clinicians in the landscape of cytopenic disorders. As for their clinical implications, the investigation of the biological significance of T- and NK-LGL clonal expansions might be crucial, especially in the setting of unexplained chronic cytopenias, as their detection and characterization could provide relevant prognostic information to properly inform therapeutic choices.
Author Contributions
Conceptualization, G.C. and E.A.; writing—original draft preparation, G.C. and E.A.; writing—review and editing, C.G., G.S., M.T.V. and R.Z. All authors have read and agreed to the published version of the manuscript.
Funding
This research received no external funding.
Institutional Review Board Statement
Not applicable.
Informed Consent Statement
Not applicable.
Data Availability Statement
The data presented in this study are available in this article.
Acknowledgments
Associazione Italiana per la Ricerca sul Cancro (AIRC), IG-20216 to G.S., and Ministero della Salute, Rome, Italy (Finalizzata 2018, NET-2018-12365935 to M.T.V.).
Conflicts of Interest
The authors declare no conflict of interest.
References
- Lamy, T.; Moignet, A.; Loughran, T.P. LGL Leukemia: From Pathogenesis to Treatment. Blood 2017, 129, 1082–1094. [Google Scholar] [CrossRef] [PubMed]
- Zawit, M.; Bahaj, W.; Gurnari, C.; Maciejewski, J. Large Granular Lymphocytic Leukemia: From Immunopathogenesis to Treatment of Refractory Disease. Cancers 2021, 13, 4418. [Google Scholar] [CrossRef]
- Gurnari, C.; Yeaney, G.A.; Kalinowski, M.; Cotta, C.V.; Maciejewski, J.P. T-Cell Large Granular Lymphocytic Leukemia Associated with Inclusion Body Myositis. Int. J. Lab. Hematol. 2022, 44, 27–28. [Google Scholar] [CrossRef] [PubMed]
- Gurnari, C.; Durrani, J.; Pagliuca, S.; Kishtagari, A.; Awada, H.; Kerr, C.M.; Adema, V.; Kongkiatkamon, S.; Lichtin, A.E.; Patel, B.J.; et al. Novel Invariant Features of Good Syndrome. Leukemia 2021, 35, 1792–1796. [Google Scholar] [CrossRef] [PubMed]
- Durrani, J.; Awada, H.; Kishtagari, A.; Visconte, V.; Kerr, C.; Adema, V.; Nagata, Y.; Kuzmanovic, T.; Hong, S.; Patel, B.; et al. Large Granular Lymphocytic Leukemia Coexists with Myeloid Clones and Myelodysplastic Syndrome. Leukemia 2020, 34, 957–962. [Google Scholar] [CrossRef]
- Moignet, A.; Lamy, T. Latest Advances in the Diagnosis and Treatment of Large Granular Lymphocytic Leukemia. Am. Soc. Clin. Oncol. Educ. Book 2018, 38, 616–625. [Google Scholar] [CrossRef]
- Zhang, D.; Loughran, T.P., Jr. Large Granular Lymphocytic Leukemia: Molecular Pathogenesis, Clinical Manifestations, and Treatment. Hematol. Am. Soc. Hematol. Educ. Program 2012, 2012, 652–659. [Google Scholar] [CrossRef]
- Huuhtanen, J.; Bhattacharya, D.; Lönnberg, T.; Kankainen, M.; Kerr, C.; Theodoropoulos, J.; Rajala, H.; Gurnari, C.; Kasanen, T.; Braun, T.; et al. Single-Cell Characterization of Leukemic and Non-Leukemic Immune Repertoires in CD8 T-Cell Large Granular Lymphocytic Leukemia. Nat. Commun. 2022, 13, 1981. [Google Scholar] [CrossRef]
- Cheon, H.; Dziewulska, K.H.; Moosic, K.B.; Olson, K.C.; Gru, A.A.; Feith, D.J.; Loughran, T.P., Jr. Advances in the Diagnosis and Treatment of Large Granular Lymphocytic Leukemia. Curr. Hematol. Malig. Rep. 2020, 15, 103–112. [Google Scholar] [CrossRef]
- Steinway, S.N.; LeBlanc, F.; Loughran, T.P., Jr. The Pathogenesis and Treatment of Large Granular Lymphocyte Leukemia. Blood Rev. 2014, 28, 87–94. [Google Scholar] [CrossRef]
- Ishida, F.; Ko, Y.H.; Kim, W.S.; Suzumiya, J.; Isobe, Y.; Oshimi, K.; Nakamura, S.; Suzuki, R. Aggressive Natural Killer Cell Leukemia: Therapeutic Potential of L-Asparaginase and Allogeneic Hematopoietic Stem Cell Transplantation. Cancer Sci. 2012, 103, 1079–1083. [Google Scholar] [CrossRef] [PubMed]
- Zambello, R.; Semenzato, G. Natural Killer Receptors in Patients with Lymphoproliferative Diseases of Granular Lymphocytes. Semin. Hematol. 2003, 40, 201–212. [Google Scholar] [CrossRef]
- Barilà, G.; Calabretto, G.; Teramo, A.; Vicenzetto, C.; Gasparini, V.R.; Semenzato, G.; Zambello, R. T Cell Large Granular Lymphocyte Leukemia and Chronic NK Lymphocytosis. Best Pract. Res. Clin. Haematol. 2019, 32, 207–216. [Google Scholar] [CrossRef] [PubMed]
- Clemente, M.J.; Wlodarski, M.W.; Makishima, H.; Viny, A.D.; Bretschneider, I.; Shaik, M.; Bejanyan, N.; Lichtin, A.E.; Hsi, E.D.; Paquette, R.L.; et al. Clonal Drift Demonstrates Unexpected Dynamics of the T-Cell Repertoire in T-Large Granular Lymphocyte Leukemia. Blood 2011, 118, 4384–4393. [Google Scholar] [CrossRef]
- Clemente, M.J.; Przychodzen, B.; Jerez, A.; Dienes, B.E.; Afable, M.G.; Husseinzadeh, H.; Rajala, H.L.M.; Wlodarski, M.W.; Mustjoki, S.; Maciejewski, J.P. Deep Sequencing of the T-Cell Receptor Repertoire in CD8+ T-Large Granular Lymphocyte Leukemia Identifies Signature Landscapes. Blood 2013, 122, 4077–4085. [Google Scholar] [CrossRef]
- Lima, M.; Almeida, J.; Santos, A.H.; dos Anjos Teixeira, M.; Alguero, M.C.; Queirós, M.L.; Balanzategui, A.; Justiça, B.; Gonzalez, M.; San Miguel, J.F.; et al. Immunophenotypic Analysis of the TCR-Vbeta Repertoire in 98 Persistent Expansions of CD3(+)/TCR-Alphabeta(+) Large Granular Lymphocytes: Utility in Assessing Clonality and Insights into the Pathogenesis of the Disease. Am. J. Pathol. 2001, 159, 1861–1868. [Google Scholar] [CrossRef]
- Muñoz-García, N.; Morán-Plata, F.J.; Villamor, N.; Lima, M.; Barrena, S.; Mateos, S.; Caldas, C.; van Dongen, J.J.M.; Orfao, A.; Almeida, J. High-Sensitive TRBC1-Based Flow Cytometric Assessment of T-Cell Clonality in Tαβ-Large Granular Lymphocytic Leukemia. Cancers 2022, 14, 408. [Google Scholar] [CrossRef]
- Zambello, R.; Falco, M.; Della Chiesa, M.; Trentin, L.; Carollo, D.; Castriconi, R.; Cannas, G.; Carlomagno, S.; Cabrelle, A.; Lamy, T.; et al. Expression and Function of KIR and Natural Cytotoxicity Receptors in NK-Type Lymphoproliferative Diseases of Granular Lymphocytes. Blood 2003, 102, 1797–1805. [Google Scholar] [CrossRef]
- Bárcena, P.; Jara-Acevedo, M.; Tabernero, M.D.; López, A.; Sánchez, M.L.; García-Montero, A.C.; Muñoz-García, N.; Vidriales, M.B.; Paiva, A.; Lecrevisse, Q.; et al. Phenotypic Profile of Expanded NK Cells in Chronic Lymphoproliferative Disorders: A Surrogate Marker for NK-Cell Clonality. Oncotarget 2015, 6, 42938–42951. [Google Scholar] [CrossRef]
- Alaggio, R.; Amador, C.; Anagnostopoulos, I.; Attygalle, A.D.; de Araujo, I.B.O.; Berti, E.; Bhagat, G.; Borges, A.M.; Boyer, D.; Calaminici, M.; et al. The 5th Edition of the World Health Organization Classification of Haematolymphoid Tumours: Lymphoid Neoplasms. Leukemia 2022, 36, 1720–1748. [Google Scholar] [CrossRef]
- Matutes, E. The 2017 WHO Update on Mature T- and Natural Killer (NK) Cell Neoplasms. Int. J. Lab. Hematol. 2018, 40 (Suppl. 1), 97–103. [Google Scholar] [CrossRef] [PubMed]
- Ishida, F. Aggressive NK-Cell Leukemia. Front. Pediatr. 2018, 6, 292. [Google Scholar] [CrossRef] [PubMed]
- Lima, M.; Almeida, J.; Dos Anjos Teixeira, M.; del Carmen Alguero, M.; Santos, A.H.; Balanzategui, A.; Queirós, M.L.; Bárcena, P.; Izarra, A.; Fonseca, S.; et al. TCRalphabeta+/CD4+ Large Granular Lymphocytosis: A New Clonal T-Cell Lymphoproliferative Disorder. Am. J. Pathol. 2003, 163, 763–771. [Google Scholar] [CrossRef]
- Barilà, G.; Teramo, A.; Calabretto, G.; Vicenzetto, C.; Gasparini, V.R.; Pavan, L.; Leoncin, M.; Vedovato, S.; Frigo, A.C.; Facco, M.; et al. Stat3 Mutations Impact on Overall Survival in Large Granular Lymphocyte Leukemia: A Single-Center Experience of 205 Patients. Leukemia 2020, 34, 1116–1124. [Google Scholar] [CrossRef] [PubMed]
- Shah, M.V.; Zhang, R.; Loughran, T.P., Jr. Never Say Die: Survival Signaling in Large Granular Lymphocyte Leukemia. Clin. Lymphoma Myeloma 2009, 9 (Suppl. 3), S244–S253. [Google Scholar] [CrossRef] [PubMed]
- Koskela, H.L.M.; Eldfors, S.; Ellonen, P.; van Adrichem, A.J.; Kuusanmäki, H.; Andersson, E.I.; Lagström, S.; Clemente, M.J.; Olson, T.; Jalkanen, S.E.; et al. Somatic STAT3 Mutations in Large Granular Lymphocytic Leukemia. N. Engl. J. Med. 2012, 366, 1905–1913. [Google Scholar] [CrossRef]
- Mariotti, B.; Calabretto, G.; Rossato, M.; Teramo, A.; Castellucci, M.; Barilà, G.; Leoncin, M.; Vicenzetto, C.; Facco, M.; Semenzato, G.; et al. Identification of a miR-Fas Ligand Axis in the Development of Neutropenia in T Large Granular Lymphocyte Leukemia. Haematologica 2020, 105, 1351–1360. [Google Scholar] [CrossRef]
- Teramo, A.; Barilà, G.; Calabretto, G.; Vicenzetto, C.; Gasparini, V.R.; Semenzato, G.; Zambello, R. Insights Into Genetic Landscape of Large Granular Lymphocyte Leukemia. Front. Oncol. 2020, 10, 152. [Google Scholar] [CrossRef]
- Teramo, A.; Barilà, G.; Calabretto, G.; Ercolin, C.; Lamy, T.; Moignet, A.; Roussel, M.; Pastoret, C.; Leoncin, M.; Gattazzo, C.; et al. STAT3 Mutation Impacts Biological and Clinical Features of T-LGL Leukemia. Oncotarget 2017, 8, 61876–61889. [Google Scholar] [CrossRef]
- Teramo, A.; Binatti, A.; Ciabatti, E.; Schiavoni, G.; Tarrini, G.; Barilà, G.; Calabretto, G.; Vicenzetto, C.; Gasparini, V.R.; Facco, M.; et al. Defining TCRγδ Lymphoproliferative Disorders by Combined Immunophenotypic and Molecular Evaluation. Nat. Commun. 2022, 13, 3298. [Google Scholar] [CrossRef]
- Barilà, G.; Grassi, A.; Cheon, H.; Teramo, A.; Calabretto, G.; Chahal, J.; Vicenzetto, C.; Almeida, J.; Shemo, B.; Min, S.; et al. Tγδ LGL leukemia identifies a subset with more symptomatic disease: Analysis of an international cohort of 137 patients. Blood 2022, in press. [Google Scholar] [CrossRef] [PubMed]
- Rajala, H.L.M.; Eldfors, S.; Kuusanmäki, H.; van Adrichem, A.J.; Olson, T.; Lagström, S.; Andersson, E.I.; Jerez, A.; Clemente, M.J.; Yan, Y.; et al. Discovery of Somatic STAT5b Mutations in Large Granular Lymphocytic Leukemia. Blood 2013, 121, 4541–4550. [Google Scholar] [CrossRef] [PubMed]
- Barilà, G.; Teramo, A.; Calabretto, G.; Ercolin, C.; Boscaro, E.; Trimarco, V.; Carraro, S.; Leoncin, M.; Vicenzetto, C.; Cabrelle, A.; et al. Dominant Cytotoxic NK Cell Subset within CLPD-NK Patients Identifies a More Aggressive NK Cell Proliferation. Blood Cancer J. 2018, 8, 51. [Google Scholar] [CrossRef] [PubMed]
- Gasparini, V.R.; Binatti, A.; Coppe, A.; Teramo, A.; Vicenzetto, C.; Calabretto, G.; Barilà, G.; Barizza, A.; Giussani, E.; Facco, M.; et al. A High Definition Picture of Somatic Mutations in Chronic Lymphoproliferative Disorder of Natural Killer Cells. Blood Cancer J. 2020, 10, 42. [Google Scholar] [CrossRef]
- Shi, M.; Olteanu, H.; Jevremovic, D.; He, R.; Viswanatha, D.; Corley, H.; Horna, P. T-Cell Clones of Uncertain Significance Are Highly Prevalent and Show Close Resemblance to T-Cell Large Granular Lymphocytic Leukemia. Implications for Laboratory Diagnostics. Mod. Pathol. 2020, 33, 2046–2057. [Google Scholar] [CrossRef]
- Dhodapkar, M.V.; Li, C.Y.; Lust, J.A.; Tefferi, A.; Phyliky, R.L. Clinical Spectrum of Clonal Proliferations of T-Large Granular Lymphocytes: A T-Cell Clonopathy of Undetermined Significance? Blood 1994, 84, 1620–1627. [Google Scholar] [CrossRef]
- Evans, H.L.; Burks, E.; Viswanatha, D.; Larson, R.S. Utility of Immunohistochemistry in Bone Marrow Evaluation of T-Lineage Large Granular Lymphocyte Leukemia. Hum. Pathol. 2000, 31, 1266–1273. [Google Scholar] [CrossRef]
- Morice, W.G.; Kurtin, P.J.; Tefferi, A.; Hanson, C.A. Distinct Bone Marrow Findings in T-Cell Granular Lymphocytic Leukemia Revealed by Paraffin Section Immunoperoxidase Stains for CD8, TIA-1, and Granzyme B. Blood 2002, 99, 268–274. [Google Scholar] [CrossRef]
- Osuji, N.; Beiske, K.; Randen, U.; Matutes, E.; Tjonnfjord, G.; Catovsky, D.; Wotherspoon, A. Characteristic Appearances of the Bone Marrow in T-Cell Large Granular Lymphocyte Leukaemia. Histopathology 2007, 50, 547–554. [Google Scholar] [CrossRef]
- Mailloux, A.W.; Zhang, L.; Moscinski, L.; Bennett, J.M.; Yang, L.; Yoder, S.J.; Bloom, G.; Wei, C.; Wei, S.; Sokol, L.; et al. Fibrosis and Subsequent Cytopenias Are Associated with Basic Fibroblast Growth Factor-Deficient Pluripotent Mesenchymal Stromal Cells in Large Granular Lymphocyte Leukemia. J. Immunol. 2013, 191, 3578–3593. [Google Scholar] [CrossRef]
- Pastoret, C.; Desmots, F.; Drillet, G.; Le Gallou, S.; Boulland, M.-L.; Thannberger, A.; Doncker, A.-V.; Salaun, V.; Damaj, G.L.; Veyrat-Masson, R.; et al. Linking the KIR Phenotype with STAT3 and TET2 Mutations to Identify Chronic Lymphoproliferative Disorders of NK Cells. Blood 2021, 137, 3237–3250. [Google Scholar] [CrossRef] [PubMed]
- Baer, C.; Kimura, S.; Rana, M.S.; Kleist, A.B.; Flerlage, T.; Feith, D.J.; Chockley, P.; Walter, W.; Meggendorfer, M.; Olson, T.L.; et al. CCL22 Mutations Drive Natural Killer Cell Lymphoproliferative Disease by Deregulating Microenvironmental Crosstalk. Nat. Genet. 2022, 54, 637–648. [Google Scholar] [CrossRef] [PubMed]
- Bhattacharya, D.; Teramo, A.; Gasparini, V.R.; Huuhtanen, J.; Kim, D.; Theodoropoulos, J.; Schiavoni, G.; Barilà, G.; Vicenzetto, C.; Calabretto, G.; et al. Identification of Novel STAT5B Mutations and Characterization of TCRβ Signatures in CD4+ T-Cell Large Granular Lymphocyte Leukemia. Blood Cancer J. 2022, 12, 31. [Google Scholar] [CrossRef] [PubMed]
- Semenzato, G.; Zambello, R. Interrogating Molecular Genetics to Refine LGLL Classification. Blood 2022, 139, 3002–3004. [Google Scholar] [CrossRef] [PubMed]
- Semenzato, G.; Pandolfi, F.; Chisesi, T.; De Rossi, G.; Pizzolo, G.; Zambello, R.; Trentin, L.; Agostini, C.; Dini, E.; Vespignani, M.; et al. The Lymphoproliferative Disease of Granular Lymphocytes. A Heterogeneous Disorder Ranging from Indolent to Aggressive Conditions. Cancer 1987, 60, 2971–2978. [Google Scholar] [CrossRef]
- Mohan, S.R.; Maciejewski, J.P. Diagnosis and Therapy of Neutropenia in Large Granular Lymphocyte Leukemia. Curr. Opin. Hematol. 2009, 16, 27–34. [Google Scholar] [CrossRef]
- Pontikoglou, C.; Kalpadakis, C.; Papadaki, H.A. Pathophysiologic Mechanisms and Management of Neutropenia Associated with Large Granular Lymphocytic Leukemia. Expert Rev. Hematol. 2011, 4, 317–328. [Google Scholar] [CrossRef]
- Calabretto, G.; Teramo, A.; Barilà, G.; Vicenzetto, C.; Gasparini, V.R.; Semenzato, G.; Zambello, R. Neutropenia and Large Granular Lymphocyte Leukemia: From Pathogenesis to Therapeutic Options. Cells 2021, 10, 2800. [Google Scholar] [CrossRef]
- Bareau, B.; Rey, J.; Hamidou, M.; Donadieu, J.; Morcet, J.; Reman, O.; Schleinitz, N.; Tournilhac, O.; Roussel, M.; Fest, T.; et al. Analysis of a French Cohort of Patients with Large Granular Lymphocyte Leukemia: A Report on 229 Cases. Haematologica 2010, 95, 1534–1541. [Google Scholar] [CrossRef]
- Sanikommu, S.R.; Clemente, M.J.; Chomczynski, P.; Afable, M.G., 2nd; Jerez, A.; Thota, S.; Patel, B.; Hirsch, C.; Nazha, A.; Desamito, J.; et al. Clinical Features and Treatment Outcomes in Large Granular Lymphocytic Leukemia (LGLL). Leuk. Lymphoma 2018, 59, 416–422. [Google Scholar] [CrossRef]
- Dong, N.; Castillo Tokumori, F.; Isenalumhe, L.; Zhang, Y.; Tandon, A.; Knepper, T.C.; Mo, Q.; Shao, H.; Zhang, L.; Sokol, L. Large Granular Lymphocytic Leukemia—A Retrospective Study of 319 Cases. Am. J. Hematol. 2021, 96, 772–780. [Google Scholar] [CrossRef] [PubMed]
- Rivero, A.; Mozas, P.; Jiménez, L.; López-Guerra, M.; Colomer, D.; Bataller, A.; Correa, J.; Rivas-Delgado, A.; Bastidas, G.; Baumann, T.; et al. Clinicobiological Characteristics and Outcomes of Patients with T-Cell Large Granular Lymphocytic Leukemia and Chronic Lymphoproliferative Disorder of Natural Killer Cells from a Single Institution. Cancers 2021, 13, 3900. [Google Scholar] [CrossRef] [PubMed]
- Salama, Y.; Zhao, F.; Oliveira, J.L.; Yuan, J.; Jevremovic, D.; Go, R.S.; Ding, W.; Parikh, S.A.; Shah, M.V.; Hampel, P.J.; et al. Isolated Anemia in Patients with Large Granular Lymphocytic Leukemia (LGLL). Blood Cancer J. 2022, 12, 30. [Google Scholar] [CrossRef] [PubMed]
- Semenzato, G.; Teramo, A.; Calabretto, G.; Gasparini, V.R.; Zambello, R. All that glitters is not LGL Leukemia. Leukemia, 2022; Online ahead of print. [Google Scholar] [CrossRef]
- Sun, H.; Wei, S.; Yang, L. Dysfunction of Immune System in the Development of Large Granular Lymphocyte Leukemia. Hematology 2019, 24, 139–147. [Google Scholar] [CrossRef]
- Gazitt, T.; Loughran, T.P., Jr. Chronic Neutropenia in LGL Leukemia and Rheumatoid Arthritis. Hematol. Am. Soc. Hematol. Educ. Program 2017, 2017, 181–186. [Google Scholar] [CrossRef]
- Liu, X.; Loughran, T.P. The Spectrum of Large Granular Lymphocyte Leukemia and Felty’s Syndrome. Curr. Opin. Hematol. 2011, 18, 254–259. [Google Scholar] [CrossRef]
- Moosic, K.B.; Ananth, K.; Andrade, F.; Feith, D.J.; Darrah, E.; Loughran, T.P., Jr. Intersection Between Large Granular Lymphocyte Leukemia and Rheumatoid Arthritis. Front. Oncol. 2022, 12, 869205. [Google Scholar] [CrossRef]
- Burks, E.J.; Loughran, T.P., Jr. Pathogenesis of Neutropenia in Large Granular Lymphocyte Leukemia and Felty Syndrome. Blood Rev. 2006, 20, 245–266. [Google Scholar] [CrossRef]
- Pflug, N.; Littauer, A.; Beverungen, D.; Sretenovic, A.; Wahnschaffe, L.; Braun, T.; Dechow, A.; Jungherz, D.; Otte, M.; Monecke, A.; et al. Case Report: Large Granular Lymphocyte Leukemia (LGLL)-A Case Series of Challenging Presentations. Front. Oncol. 2021, 11, 775313. [Google Scholar] [CrossRef]
- Alfano, G.; Ferrari, A.; Fontana, F.; Damiano, F.; Solazzo, A.; Mori, G.; Cappelli, G. Hemolytic Anemia as Presentation of T-Cell Large Granular Lymphocytic Leukemia After Kidney Transplantation: A Case Report. Transplant. Proc. 2020, 52, 1617–1618. [Google Scholar] [CrossRef] [PubMed]
- Gentile, T.C.; Loughran, T.P., Jr. Resolution of Autoimmune Hemolytic Anemia Following Splenectomy in CD3+ Large Granular Lymphocyte Leukemia. Leuk. Lymphoma 1996, 23, 405–408. [Google Scholar] [CrossRef] [PubMed]
- Gurnari, C.; Maciejewski, J.P. How I Manage Acquired Pure Red Cell Aplasia in Adults. Blood 2021, 137, 2001–2009. [Google Scholar] [CrossRef] [PubMed]
- Bockorny, B.; Dasanu, C.A. Autoimmune Manifestations in Large Granular Lymphocyte Leukemia. Clin. Lymphoma Myeloma Leuk. 2012, 12, 400–405. [Google Scholar] [CrossRef]
- Osuji, N.; Matutes, E.; Catovsky, D.; Lampert, I.; Wotherspoon, A. Histopathology of the Spleen in T-Cell Large Granular Lymphocyte Leukemia and T-Cell Prolymphocytic Leukemia: A Comparative Review. Am. J. Surg. Pathol. 2005, 29, 935–941. [Google Scholar] [CrossRef]
- Ergas, D.; Tsimanis, A.; Shtalrid, M.; Duskin, C.; Berrebi, A. T-γ Large Granular Lymphocyte Leukemia Associated with Amegakaryocytic Thrombocytopenic Purpura, Sjögren’s Syndrome, and Polyglandular Autoimmune Syndrome Type II, with Subsequent Development of Pure Red Cell Aplasia. Am. J. Hematol. 2002, 69, 132–134. [Google Scholar] [CrossRef]
- Lai, D.W.; Loughran, T.P., Jr.; Maciejewski, J.P.; Sasu, S.; Song, S.X.; Epling-Burnette, P.K.; Paquette, R.L. Acquired Amegakaryocytic Thrombocytopenia and Pure Red Cell Aplasia Associated with an Occult Large Granular Lymphocyte Leukemia. Leuk. Res. 2008, 32, 823–827. [Google Scholar] [CrossRef]
- Fattizzo, B.; Bellani, V.; Pasquale, R.; Giannotta, J.A.; Barcellini, W. Large Granular Lymphocyte Expansion in Myeloid Diseases and Bone Marrow Failure Syndromes: Whoever Seeks Finds. Front. Oncol. 2021, 11, 748610. [Google Scholar] [CrossRef]
- Komrokji, R.S.; Ali, N.A.; Sallman, D.; Padron, E.; Lancet, J.; Sokol, L.; Varnadoe, C.; Burnette, P.K.; List, A. Characterization of Myelodysplastic Syndromes (MDS) with T-Cell Large Granular Lymphocyte Proliferations (LGL). Leukemia 2020, 34, 3097–3099. [Google Scholar] [CrossRef]
- Nyland, S.B.; Krissinger, D.J.; Clemente, M.J.; Irby, R.B.; Baab, K.T.; Jarbadan, N.R.; Sokol, L.; Schaefer, E.; Liao, J.; Cuthbertson, D.; et al. Seroreactivity to LGL Leukemia-Specific Epitopes in Aplastic Anemia, Myelodysplastic Syndrome and Paroxysmal Nocturnal Hemoglobinuria: Results of a Bone Marrow Failure Consortium Study. Leuk. Res. 2012, 36, 581–587. [Google Scholar] [CrossRef]
- Raess, P.W.; Cascio, M.J.; Fan, G.; Press, R.; Druker, B.J.; Brewer, D.; Spurgeon, S.E. Concurrent STAT3, DNMT3A, and TET2 Mutations in T-LGL Leukemia with Molecularly Distinct Clonal Hematopoiesis of Indeterminate Potential. Am. J. Hematol. 2017, 92, E6–E8. [Google Scholar] [CrossRef] [PubMed]
- Isabelle, C.; Boles, A.; Chakravarti, N.; Porcu, P.; Brammer, J.; Mishra, A. Cytokines in the Pathogenesis of Large Granular Lymphocytic Leukemia. Front. Oncol. 2022, 12, 849917. [Google Scholar] [CrossRef] [PubMed]
- Calabretto, G.; Attardi, E.; Teramo, A.; Trimarco, V.; Carraro, S.; Mossuto, S.; Barilà, G.; Vicenzetto, C.; Gasparini, V.R.; Crugnola, M.; et al. Hypocellular Myelodysplastic Syndromes (h-MDS): From Clinical Description to Immunological Characterization in the Italian Multi-Center Experience. Leukemia 2022, 36, 1947–1950. [Google Scholar] [CrossRef]
- Cazzola, M. Myelodysplastic Syndromes. Reply. N. Engl. J. Med. 2020, 383, 2590. [Google Scholar] [CrossRef]
- Arber, D.A.; Orazi, A.; Hasserjian, R.; Thiele, J.; Borowitz, M.J.; Le Beau, M.M.; Bloomfield, C.D.; Cazzola, M.; Vardiman, J.W. The 2016 Revision to the World Health Organization Classification of Myeloid Neoplasms and Acute Leukemia. Blood 2016, 127, 2391–2405. [Google Scholar] [CrossRef]
- Fattizzo, B.; Serpenti, F.; Barcellini, W.; Caprioli, C. Hypoplastic Myelodysplastic Syndromes: Just an Overlap Syndrome? Cancers 2021, 13, 132. [Google Scholar] [CrossRef]
- Zhang, H.-F.; Huang, Z.-D.; Wu, X.-R.; Li, Q.; Yu, Z.-F. Comparison of T Lymphocyte Subsets in Aplastic Anemia and Hypoplastic Myelodysplastic Syndromes. Life Sci. 2017, 189, 71–75. [Google Scholar] [CrossRef]
- Ogata, K.; Della Porta, M.G.; Malcovati, L.; Picone, C.; Yokose, N.; Matsuda, A.; Yamashita, T.; Tamura, H.; Tsukada, J.; Dan, K.; et al. Diagnostic Utility of Flow Cytometry in Myelodysplastic Syndromes: A Prospective Validation Study in Low-Risk Patients with Normal Karyotype. Blood 2008, 112, 3634. [Google Scholar] [CrossRef]
- Mathis, S.; Chapuis, N.; Debord, C.; Rouquette, A.; Radford-Weiss, I.; Park, S.; Dreyfus, F.; Lacombe, C.; Béné, M.C.; Kosmider, O.; et al. Flow Cytometric Detection of Dyserythropoiesis: A Sensitive and Powerful Diagnostic Tool for Myelodysplastic Syndromes. Leukemia 2013, 27, 1981–1987. [Google Scholar] [CrossRef]
- Jerez, J.; Ocqueteau, M. Immunophenotype of Erythroid Precursors in Patient with Pure Red Cell Aplasia (PRCA): Utility of Analysis of Erythroid Maturation. Ann. Hematol. Oncol. 2021, 8, 1346. [Google Scholar]
- Gurnari, C.; Graham, A.C.; Efanov, A.; Pagliuca, S.; Durrani, J.; Awada, H.; Patel, B.J.; Lichtin, A.E.; Visconte, V.; Sekeres, M.A.; et al. Frequency and Perturbations of Various Peripheral Blood Cell Populations before and after Eculizumab Treatment in Paroxysmal Nocturnal Hemoglobinuria. Blood Cells Mol. Dis. 2021, 87, 102528. [Google Scholar] [CrossRef] [PubMed]
- Gupta, S.K.; Pati, H.P.; Tejomurtula, A.P.; Seth, T. PNH Clone Assessment by Flow Cytometry and Its Clinical Correlation in PNH and Aplastic Anemia. J. Hematop. 2010, 3, 137–143. [Google Scholar] [CrossRef]
- Bono, E.; McLornan, D.; Travaglino, E.; Gandhi, S.; Gallì, A.; Khan, A.A.; Kulasekararaj, A.G.; Boveri, E.; Raj, K.; Elena, C.; et al. Clinical, Histopathological and Molecular Characterization of Hypoplastic Myelodysplastic Syndrome. Leukemia 2019, 33, 2495–2505. [Google Scholar] [CrossRef]
- Voso, M.T.; Gurnari, C. Have We Reached a Molecular Era in Myelodysplastic Syndromes? Hematol. Am. Soc. Hematol. Educ. Program 2021, 2021, 418–427. [Google Scholar] [CrossRef]
- DeZern, A.E.; Malcovati, L.; Ebert, B.L. CHIP, CCUS, and Other Acronyms: Definition, Implications, and Impact on Practice. Am. Soc. Clin. Oncol. Educ. Book 2019, 39, 400–410. [Google Scholar] [CrossRef]
- Jerez, A.; Clemente, M.J.; Makishima, H.; Rajala, H.; Gómez-Seguí, I.; Olson, T.; McGraw, K.; Przychodzen, B.; Kulasekararaj, A.; Afable, M.; et al. STAT3 Mutations Indicate the Presence of Subclinical T-Cell Clones in a Subset of Aplastic Anemia and Myelodysplastic Syndrome Patients. Blood 2013, 122, 2453–2459. [Google Scholar] [CrossRef]
- Ai, K.; Li, M.; Wu, P.; Deng, C.; Huang, X.; Ling, W.; Xu, R.; Geng, S.; Sun, Q.; Weng, J.; et al. Concurrence of Myelodysplastic Syndromes and Large Granular Lymphocyte Leukemia: Clinicopathological Features, Mutational Profile and Gene Ontology Analysis in a Single Center. Am. J. Cancer Res. 2021, 11, 1616–1631. [Google Scholar]
- Yoshizato, T.; Dumitriu, B.; Hosokawa, K.; Makishima, H.; Yoshida, K.; Townsley, D.; Sato-Otsubo, A.; Sato, Y.; Liu, D.; Suzuki, H.; et al. Somatic Mutations and Clonal Hematopoiesis in Aplastic Anemia. N. Engl. J. Med. 2015, 373, 35–47. [Google Scholar] [CrossRef]
- Gurnari, C.; Pagliuca, S.; Prata, P.H.; Galimard, J.-E.; Catto, L.F.B.; Larcher, L.; Sebert, M.; Allain, V.; Patel, B.J.; Durmaz, A.; et al. Clinical and Molecular Determinants of Clonal Evolution in Aplastic Anemia and Paroxysmal Nocturnal Hemoglobinuria. J. Clin. Oncol. 2022, 138, JCO2200710. [Google Scholar] [CrossRef]
- Goyal, T.; Tu, Z.J.; Wang, Z.; Cook, J.R. Clinical and Pathologic Spectrum of DDX41-Mutated Hematolymphoid Neoplasms. Am. J. Clin. Pathol. 2021, 156, 829–838. [Google Scholar] [CrossRef]
- Pilania, R.K.; Banday, A.Z.; Sharma, S.; Kumrah, R.; Joshi, V.; Loganathan, S.; Dhaliwal, M.; Jindal, A.K.; Vignesh, P.; Suri, D.; et al. Deficiency of Human Adenosine Deaminase Type 2—A Diagnostic Conundrum for the Hematologist. Front. Immunol. 2022, 13, 869570. [Google Scholar] [CrossRef] [PubMed]
- Dorjbal, B.; Stinson, J.R.; Ma, C.A.; Weinreich, M.A.; Miraghazadeh, B.; Hartberger, J.M.; Frey-Jakobs, S.; Weidinger, S.; Moebus, L.; Franke, A.; et al. Hypomorphic Caspase Activation and Recruitment Domain 11 (CARD11) Mutations Associated with Diverse Immunologic Phenotypes with or without Atopic Disease. J. Allergy Clin. Immunol. 2019, 143, 1482–1495. [Google Scholar] [CrossRef] [PubMed]
- Rajpurkar, M.; Buck, S.; Lafferty, J.; Wakeling, E.; Ravindranath, Y.; Savaşan, S. Acquired Pure Red Cell Aplasia and Acquired Amegakaryocytic Thrombocytopenia Associated With Clonal Expansion of T-Cell Large Granular Lymphocytes in a Patient With Lipopolysaccharide-Responsive Beige-like Anchor (LRBA) Protein Deficiency. J. Pediatr. Hematol./Oncol. 2019, 41, e542–e545. [Google Scholar] [CrossRef] [PubMed]
- Aluri, J.; Bach, A.; Kaviany, S.; Chiquetto Paracatu, L.; Kitcharoensakkul, M.; Walkiewicz, M.A.; Putnam, C.D.; Shinawi, M.; Saucier, N.; Rizzi, E.M.; et al. Immunodeficiency and Bone Marrow Failure with Mosaic and Germline TLR8 Gain of Function. Blood 2021, 137, 2450–2462. [Google Scholar] [CrossRef] [PubMed]
- Bleesing, J. Gain-of-Function Defects in Toll-like Receptor 8 Shed Light on the Interface between Immune System and Bone Marrow Failure Disorders. Front. Immunol. 2022, 13, 935321. [Google Scholar] [CrossRef]
- Wehr, C.; Houet, L.; Unger, S.; Kindle, G.; Goldacker, S.; Grimbacher, B.; de Oteyza, A.C.G.; Marks, R.; Pfeifer, D.; Nieters, A.; et al. Altered Spectrum of Lymphoid Neoplasms in a Single-Center Cohort of Common Variable Immunodeficiency with Immune Dysregulation. J. Clin. Immunol. 2021, 41, 1250–1265. [Google Scholar] [CrossRef]
- Kitchen, B.J.; Boxer, L.A. Large Granular Lymphocyte Leukemia (LGL) in a Child with Hyper IgM Syndrome and Autoimmune Hemolytic Anemia. Pediatr. Blood Cancer 2008, 50, 142–145. [Google Scholar] [CrossRef]
- Attardi, E.; Di Cesare, S.; Amodio, D.; Giancotta, C.; Cotugno, N.; Cifaldi, C.; Chiriaco, M.; Palma, P.; Finocchi, A.; Di Matteo, G.; et al. Phenotypical T Cell Differentiation Analysis: A Diagnostic and Predictive Tool in the Study of Primary Immunodeficiencies. Front. Immunol. 2019, 10, 2735. [Google Scholar] [CrossRef]
- Schiavo, E.; Martini, B.; Attardi, E.; Consonni, F.; Ciullini Mannurita, S.; Coniglio, M.L.; Tellini, M.; Chiocca, E.; Fotzi, I.; Luti, L.; et al. Autoimmune Cytopenias and Dysregulated Immunophenotype Act as Warning Signs of Inborn Errors of Immunity: Results From a Prospective Study. Front. Immunol. 2021, 12, 790455. [Google Scholar] [CrossRef]
Publisher’s Note: MDPI stays neutral with regard to jurisdictional claims in published maps and institutional affiliations. |
© 2022 by the authors. Licensee MDPI, Basel, Switzerland. This article is an open access article distributed under the terms and conditions of the Creative Commons Attribution (CC BY) license (https://creativecommons.org/licenses/by/4.0/).